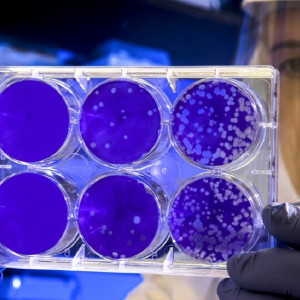
Во Владимирской области заболеваемость ковидом выросла до 33 случаев

В шести домах Владимира временно отключили тепло
На Верхней Дуброве ремонтируют теплосети.

На Верхней Дуброве ремонтируют теплосети.

Территория разрастется до платника М-12.

Однако документ пока не опубликован.

Погибших нет.
В шести районах инфицированных нет.

ДТП произошло на Студеной горе.

Светлана Арлашина будет работать в министерстве образования.

ДТП произошло на Двориковском шоссе.

Приметы и традиции народного календаря.

По расчетам, население вырастет в четыре раза.

Четыре автомобилиста погибли.

Однако признали необходимость доработок.

Мужчина хранил самодельный огнестрел в сарае.

Водителей попросили убрать машины.

Автомобилист не уступил дорогу.

Машины принадлежали одной компании.

Предложение в 3,5 раза превышает спрос.

Пострадал 39-летний водитель.

В медучреждении назначили дежурство бригад по дням.

Проект вынесен на обсуждение.